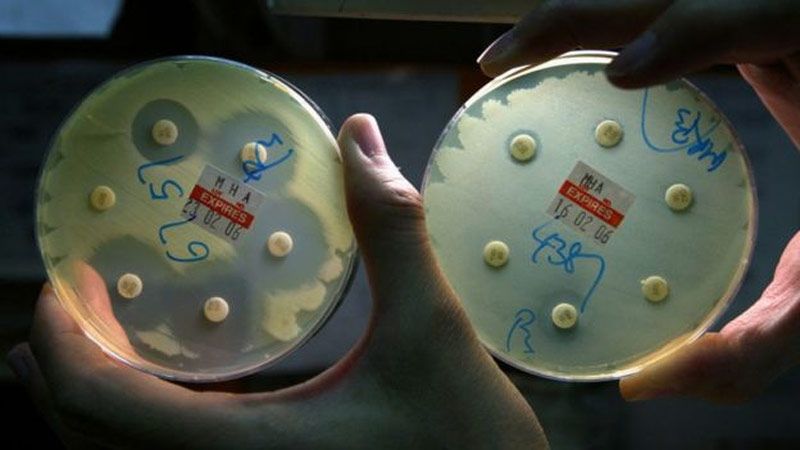

Turismo médico en México, Tijuana se convirtió en el "quirófano" de los estadounidenses, con precios entre 30% y 70% menos respecto a EE.UU.
Ramsés Q. no lo dudó mucho cuando le dijeron que la cirugía oftalmológica para su hijo Andrés le costaría hasta 70% menos en Tijuana.
Este padre de una familia de latinos residentes en el área de San José, California, viajó ocho horas por carretera para llegar a consulta a un hospital de esa ciudad mexicana fronteriza con EE.UU.
Andrés necesita una cirugía correctiva que en Tijuana le costará unos US$3.500 en lugar de los más de US$11.000 que le dijeron en los hospitales del área de San Francisco.
"La realidad es que no hay mucho qué pensar. Allá (EE.UU.) te puede costar miles y miles de dólares y uno mira y es casi lo mismo", le dice el padre de familia a BBC Mundo desde una sala de la clínica SIMNSA.

Este centro hospitalario es uno de los que diariamente recibe a los cientos de pacientes extranjeros -casi todos de Estados Unidos- que llegan a Tijuana para someterse a tratamientos médicos.
La ola del llamado"turismo médico" ha sido tan grande en los últimos años que esta ciudad recibió en 2018 alrededor de 1,2 millones de pacientes que llegaron buscando tratamiento de salud.
Con sus acompañantes, se calcula que la ciudad recibe más de 2,5 millones de personas vinculadas con la búsqueda de médicos.
Es un gran crecimiento respecto a cuatro años antes, cuando se contabilizaron 800.000 visitantes, cifras que hacen a los tijuanenses considerarse como la "capital del turismo médico".
"Siempre ha existido el turismo médico en Tijuana, pero no en la magnitud en la que estamos viviéndolo ahora", le dice a BBC Mundo Gilberto Leyva, presidente del Comité de Turismo y Convenciones (Cotuco).
La ciudad vive una transformación, con nuevos hospitales, consultorios, centros comerciales y hasta hoteles con camas de hospital para recuperaciones, la industria de mayor crecimiento e inversión actualmente.
Los bajos costos de consultas, procedimientos, fármacos y cirugías -precios entre 30% y 70% menos respecto a EE.UU.- hacen que esta ciudad prospere como un gran centro de salud.
"Además hay una relación más cercana, el trato es más amigable, más tibio, más personal. Eso está dentro del atractivo en los servicios de salud, el factor humano", dice a BBC Mundo Ricardo Vega, presidente del Clúster de Servicios de Salud estatal.
Pero el boom de estos servicios no ha estado exento de controversias.
Hasta inicios de abril se mantiene una alerta de autoridades sanitarias de EE.UU. dados los casos de "infecciones graves" cuyo presunto origen se dio en un hospital de Tijuana.
Además, los tijuanenses luchan contra la estigma de ser considerada en un ranking publicado en marzo como la "ciudad más violenta del mundo".
Ciudad consultorio
Al caminar por las calles de Tijuana es casi imposible no encontrarse con llamativos letreros -la mayoría en inglés- que invitan a los transeúntes a visitar a un médico.
En general los consultorios en el centro de la ciudad son de odontólogos que ofrecen sus servicios a los estadounidenses de California, en donde se ubican grandes ciudades como San Diego, Los Ángeles, San José y San Francisco.
Pero en esta área y en la zona comercial Río también hay grandes anuncios de hospitales y farmacias que ofrecen sus servicios para todo tipo de procedimientos médicos.
Es una industria que no es nueva, pero que está en gran expansión.
Desde mediados del siglo XX, los estadounidenses cruzaban la frontera hacia Tijuana para obtener tratamientos de salud a bajo costo, así como "terapias alternativas", explica el médico Ricardo Vega.
"Esa gestación dio al Tijuana de hoy en el tema médico, a un Tijuana que tiene tecnología avanzada, experiencia con especialistas. La ventaja que tiene la situación geográfica de Tijuana va de la mano con el desarrollo de tecnología, la oferta de infraestructura -hospitales y clínicas- y el expertise de los especialistas", añade.
Entre esta ciudad y la vecina Mexicali -también fronteriza con EE.UU.- cada mes hay unas 40.000 consultas médicas, según los números del Clúster de Servicios de Salud de Baja California.
Esto generó el año pasado una derrama económica de unos US$1.400 millones, a la cual se suma una inversión por un monto similar para la construcción y remodelación de clínicas privadas.
"El aumento en los últimos dos años en la infraestructura de salud supera losUS$1.500 millones, nada más en nuevas clínicas, hospitales, remodelaciones. Es muy frecuente que estén llegando médicos nuevos", explica Vega.
Indicadores de Cotuco muestran que el gran crecimiento durante esta década ha venido de la mano delas limitaciones cada vez mayores de los seguros médicos en Estados Unidos.
"Muchas facilidades son las que les han quitado a los estadounidenses para recibir tratamiento, les han cortado muchos beneficios. Toda esa gente que no puede pagar, viene a atenderse aquí en Tijuana", dice Gilberto Leyva.
¿Qué buscan los pacientes?
Antonella R. es una estadounidense que visita Tijuana para practicarse uno de los procedimientos quirúrgicos más solicitados: una cirugía estética mamaria.
Mientras que en su país el procedimiento puede tener un costo superior a US$10.000, en la ciudad mexicana promedia unos US$3.500.
"Sí implica un gasto (adicional) por el viaje y el hotel y la estancia. Pero tengo confianza en el procedimiento, me gustan las opciones que me ofrecen y el tratamiento en general", dice la paciente.
La mujer dice que contrató un paquete en el área de Los Ángeles que le ofrecía todos los servicios para llevarla desde su casa hasta el hospital y de regreso, algo así como un "todo incluido" de los balnearios.
La idea de crear "paquetes" para atraer pacientes es parte de las estrategias que han generado los médicos en Tijuana para hacer crecer el turismo médico.
Pero también se considera que hay otra publicidad que les ha sido más provechosa: las recomendaciones boca a boca.
"Le estamos apostando mucho a los testimonios. Les pedimos a los médicos que saquen los testimonios a sus pacientes, de que está seguro, de que está contento. Y eso nos ayuda a divulgar", dice Gilberto Leyva, de Cotuco.
De acuerdo con el Clúster de Servicios de Salud, en Tijuana cada día se practican 350 cirugías plásticas y 80 de bariatría (para el control de la obesidad).
"El número de procedimientos y el número de consultas es tan alto, y la experiencia es tan buena en 90% o más de los pacientes, que eso es una luz muy grande de atracción para venir a hacerse procedimientos aquí", dice el médico Ricardo Vega.

Incluso las autoridades de México y EE.UU. establecieron un "carril médico" para el paso de pacientes y sus familiasen una frontera en la que el cruce en auto puede demorar entre dos y cuatro horas, en promedio.
Pero el gran crecimiento del turismo médico se impactó este año con dos noticias que han generado incertidumbre y hasta enfado en el sector.
¿Ciudad peligrosa?
La publicación del ranking de "Las 50 ciudades más violentas del mundo en 2018" el mes pasado golpeó la imagen de toda la ciudad, y por ende al turismo.
Ese estudio, divulgado anualmente por el Consejo Ciudadano para la Seguridad Pública y la Justicia Penal, coloca a Tijuana en el número uno dada la tasa de homicidios de 138,26 por cada 100.000 habitantes, 28 puntos encima del segundo lugar (110,50).
Caminar por las calles turísticas del centro y la zona de Río resulta agradable, pero los propios tijuanenses advierten a los visitantes que hay que tener cuidado en la Zona Norte cercana a la valla fronteriza o salir de las zonas comerciales.
El presidente de Cotuco, Gilberto Leyva, rechaza la metodología del ranking, pero además asegura que el área donde se ubican la mayoría de las clínicas está "blindada" por policías bilingües.
Otra noticia, sin embargo, es aún más dura.
El caso Grand View
Los Centros para el Control y la Prevención de Enfermedades de EE.UU. (CDC, por sus siglas en inglés) publicaron una alerta sanitaria en diciembre -vigente actualmente-sobre el caso de una bacteria procedente de un hospital de Tijuana.
"Los CDC han recibido informes de infecciones gravespor Pseudomonas aeruginosa resistentes a los medicamentos en residentes de EE.UU. Tuvieron procedimientos médicos invasivos (principalmente cirugía para perder peso) en Tijuana, México", detalla.
En particular señala que "más de la mitad de las personas infectadas" -16 pacientes, detalló un portavoz a BBC Mundo- tuvieron cirugías en el Hospital Grand View, mientras que "los otros se infectaron después de la cirugía en otros hospitales y clínicas".
Grand View fue cerrado durante diciembre y enero tras la alerta de CDC y las inspecciones de autoridades queencontraron fallas en protocolos de registros de esterilización, limpieza de quipo de laparoscopía, lavado de manos y otras falencias administrativas.
Pero la bacteria "no fue encontrada en el hospital, no encontramos evidencia de infección activa en los sitios quirúrgicos", le dice el jefe estatal de Epidemiología de Baja California, Oscar Zazueta, a BBC Mundo.
"Las infecciones nosocomiales son un problema que lo tienen todos los hospitales del mundo. Las principales bacterias en los hospitales son Pseudomonas aeruginosas, como en este caso. Lo que llamó la atención en este hospital fueuna variación genética que tenía la bacteria", explica.
Grand View asegura que las observaciones fueron solventadas y por ello reabrió en febrero pasado.
Un portavoz de los CDC, donde sus pruebas sí dieron positivo, dijo a BBC Mundo a principios de abril que "el brote está en curso" y por ello mantienen su alerta para que las personas "estén conscientes del riesgo de infección" en ese hospital.
Para el líder de los médicos de Tijuana, Ricardo Vega, esta situación fue atendida y controlada, pero considera que los CDC lo magnificaron y publicitaron de forma inusual.
"Infecciones intrahospitalarias en todo el mundo hay. Allá (EE.UU.) son altísimas, hay muertes registradas en hospitales. No es normal que le den una publicidad, no es normal unas alertas tan frecuentes", considera Vega.
Confianza
Los líderes del turismo médico en Tijuana dicen que el mejor respaldo a su trabajo es la confianza que han mostrado los pacientes que no han dejado de llegar en los últimos años.
La industria ha crecido a tal ritmo que ahora los hoteles han comenzado crear habitaciones con camas de hospital y otras facilidades para pacientes convalecientes.
Algunos expertos del estado como el médico Álvaro de Lachica han advertido que hay riesgos para la salud de los pacientes si no toman las medidas de convalecencia adecuadas.
"Hay un período de recuperación y seguimiento, para que el cirujano evalúe los resultados y se asegure de que todo está progresando normalmente (...) Las complicaciones son parte de las cirugías", advierte Lachica.

En el Grand Hotel aseguran que solo aceptan pacientes "con cirugías o tratamiento que sea de una rápida recuperación (3 días)".
"El paciente o huésped está en permanente contacto con su médico y se cuenta con líneas directas de teléfono y emergencia para que atiendan de inmediato".
Sin embargo, el jefe de Protección Contra Riesgos Sanitarios estatal, Héctor Rivera, advirtió a BBC Mundo que hoy "no existe tramite o autorización alguna para que un hotel preste servicios de instalaciones y estancia para recuperación de enfermos".
A pesar de los problemas vistos este año, en Tijuana la asociación médico-empresarial busca que la confianza en su destino no decaiga, e incluso siga aumentando.
"Los mismos empresarios de otros rubros, gastronomía, hotelería, están apostando al turismo médico. Otras partes del mundo han volteado a ver a Tijuana", dice Niral Basave, del desarrollo NewCity Medical Plaza, la torre médica más grande que tendrá la ciudad.
"Tenemos la ventaja de estar en la puerta de México y queremos proyectar a Tijuana".